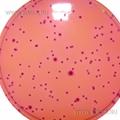
Violet Red Bile Agar with MUG (VRBA with MUG)
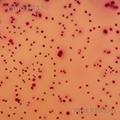
Violet Red Bile Glucose Agar (VRBGA)
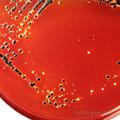
XLD Agar (Xylose Lysine Decarboxylase)
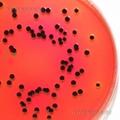
XLT4 Agar (Xylose Lysine Tergitol4)
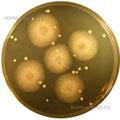
Yeast Extract Dextrose Chloramphenicol Agar

Подписаться на рассылку
Компания СИМАС
Москва, Варшавское шоссе д.125 стр.1
+7 (495) 980 - 29 - 37, +7 (916) 942 - 65 - 95
info@simas.ru
|
Полный перечень сред Lab M
1 | 2 | 3 | 4 | 5 | 6 | 7
TYC Medium (Tryptone Yeast Cystine)
 Производитель: Lab M
Описание: Агар триптонно-дрожжевой с цистином для дифференциации стрептококков видов Streptococcus sanguis и Streptococcus mutants.
Этап: Исследование |
|
|
|
Urea Agar Base (Christensen´s Urea Base)
 Производитель: Lab M
Описание: Агар с мочевиной по Кристенсену для выявления уреазопродуцирующих бактерий.
Этап: Исследование |
|
|
|
Urea Broth Base
 Производитель: Lab M
Описание: Бульон с мочевиной (жидкий вариант агара с мочевиной LAB130) для выявления уреазопродуцирующих бактерий при использовании больших инокулятов штаммов.
Этап: Исследование |
|
|
|
UVM Base Medium (University of Vermont)
 Производитель: Lab M
Описание: Среда для 2-х стадийного обогащения листерий (в соотв. с требованиями Фармакопеи США).
Этап: Исследование |
|
|
|
Violet Red Bile Agar (VRBA)
 Производитель: Lab M
Описание: Агар желчный с лактозой и фиолетовым красным для подсчета колиформных бактерий в молочных и др. продуктах.
Этап: Исследование |
|
|
|
Violet Red Bile Agar with MUG (VRBA with MUG)
Производитель: Lab M
Описание: Агар желчный с лактозой, фиолетовым красным и с люминогеном MUG для одновременного подсчета колиформных бактерий и E.coli.
Этап: Исследование |
|
|
|
Violet Red Bile Glucose Agar (VRBGA)
Производитель: Lab M
Описание: Агар желчный с глюкозой и фиолетовым красным для подсчета энтеробактерий в молочных и др. продуктах.
Этап: Исследование |
|
|
|
W.L. Nutrient Agar (Wallerstein Laboratory)
 Производитель: Lab M
Описание: Агар Валерштайна для подсчета микроорганизмов при производстве пива.
Этап: Исследование |
|
|
|
Water Plate Count Agar
 Производитель: Lab M
Описание: Агар неселективный для подсчета бактерий в воде по стандарту ISO 6222:1999(E).
Этап: Исследование |
|
|
|
Wort Agar
 Производитель: Lab M
Описание: Cусло-агар для подсчета дрожжей и плесеней (с возможностью изменения осмофильных условий).
Этап: Исследование |
|
|
|
Wort Broth
 Производитель: Lab M
Описание: Сусло-бульон для подсчета дрожжей и плесеней (с возможностью изменения осмофильных условий).
Этап: Исследование |
|
|
|
XLD Agar (Xylose Lysine Decarboxylase)
Производитель: Lab M
Описание: Агар ксилозо-лизиновый для селективного выделения шигелл и сальмонелл.
Этап: Исследование |
|
|
|
XLT4 Agar (Xylose Lysine Tergitol4)
Производитель: Lab M
Описание: Агар ксилозно-лизиновый с тергитолом-4 для дифференциального выделения сальмонелл.
Этап: Исследование |
|
|
|
Yeast and Mould Agar
 Производитель: Lab M
Описание: Агар для выделения и подсчета дрожжей и плесеней.
Этап: Исследование |
|
|
|
Yeast Extract Agar (Yeastrel Milk Agar)
 Производитель: Lab M
Описание: Агар с дрожжевым экстрактом (молочно-дрожжжевой агар) для подсчета микроорганизмов в воде и молочных продуктах.
Этап: Исследование |
|
|
|
Yeast Extract Dextrose Chloramphenicol Agar
Производитель: Lab M
Описание: Агар дрожжевой с декстрозой и хлорамфениколом для селективного выделения и подсчета дрожжей и грибов в молочных продуктах.
Этап: Исследование |
|
|
|
Yersinia Selective Agar (Schiemanns C.I.N. Agar)
 Производитель: Lab M
Описание: Агар cелективный для выделения йерсиний (C.I.N.-агар Шимманса).
Этап: Исследование |
|
|
|
YPD Agar
 Производитель: Lab M
Описание: Агаг питательный для культивирования и сохранения дрожжей.
Этап: Исследование |
|
|
|
YPD Broth
 Производитель: Lab M
Описание: Бульон питательный для культивирования и сохранения дрожжей.
Этап: Исследование |
|
|
|
2xYT Medium
 Производитель: Lab M
Описание: Бульон для выращивания клеток-хозяев для нитчатых одноцепочечных. бактериофагов.
Этап: Исследование |
|
|
|
2xYT with Agar
 Производитель: Lab M
Описание: Cреда с агаром для выращивания клеток-хозяев для нитчатых одноцепочечных бактериофагов.
Этап: Исследование |
|
|
|
1 | 2 | 3 | 4 | 5 | 6 | 7
|